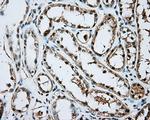
ARNT Antibody in Immunohistochemistry (Paraffin) (IHC (P))

Search
OriGene
ARNT Monoclonal Antibody (OTI1F4), TrueMAB™
{{$productOrderCtrl.translations['antibody.pdp.commerceCard.promotion.promotions']}}
{{$productOrderCtrl.translations['antibody.pdp.commerceCard.promotion.viewpromo']}}
{{$productOrderCtrl.translations['antibody.pdp.commerceCard.promotion.promocode']}}: {{promo.promoCode}} {{promo.promoTitle}} {{promo.promoDescription}}. {{$productOrderCtrl.translations['antibody.pdp.commerceCard.promotion.learnmore']}}
产品信息
TA501149
种属反应
宿主/亚型
分类
类型
克隆号
抗原
偶联物
形式
浓度
纯化类型
保存液
内含物
保存条件
运输条件
靶标信息
HIF-1 beta is a series of aryl hydrocarbon receptor nuclear translocator (ARNT) gene products. Hypoxia contributes significantly to the pathophysiology of major categories of human disease, including myocardial and cerebral ischemia, cancer, pulmonary hypertension, congenital heart disease and chronic obstructive pulmonary disease. Hypoxia contributes significantly to the pathophysiology of major categories of human disease, including myocardial and cerebral ischemia, cancer, pulmonary hypertension, congenital heart disease and chronic obstructive pulmonary disease. HIF-1 is a nuclear protein involved in mammalian oxygen homeostasis. This occurs as a posttranslational modification by prolyl hydroxylation. HIF-1 is a heterodimer composed of HIF-1 alpha and HIF-1 beta subunits. Both subunits are constantly translated. However, under normoxic conditions, human HIF-1 alpha is hydroxylated at Pro402 or Pro564 by a set of HIF prolyl hydroxylases, is polyubiquinated, and eventually degraded in proteosomes. Under hypoxic conditions, the lack of hydroxylation prevents HIF degradation and increases transcriptional activity. Therefore, the concentration of HIF-1 alpha increases in the cell. In contrast, HIF-1 beta remains stable under either condition. HIF-1 beta is a series of aryl hydrocarbon receptor nuclear translocator (ARNT) gene products. Diseases associated with HIF-1 beta dysfunction include hypoxia and renal cell carcinoma.HIF-1 beta is a series of aryl hydrocarbon receptor nuclear translocator (ARNT) gene products. Hypoxia contributes significantly to the pathophysiology of major categories of human disease, including myocardial and cerebral ischemia, cancer, pulmonary hypertension, congenital heart disease and chronic obstructive pulmonary disease. Hypoxia contributes significantly to the pathophysiology of major categories of human disease, including myocardial and cerebral ischemia, cancer, pulmonary hypertension, congenital heart disease and chronic obstructive pulmonary disease. HIF-1 is a nuclear protein involved in mammalian oxygen homeostasis. This occurs as a posttranslational modification by prolyl hydroxylation. HIF-1 is a heterodimer composed of HIF-1 alpha and HIF-1 beta subunits. Both subunits are constantly translated. However, under normoxic conditions, human HIF-1 alpha is hydroxylated at Pro402 or Pro564 by a set of HIF prolyl hydroxylases, is polyubiquinated, and eventually degraded in proteosomes. Under hypoxic conditions, the lack of hydroxylation prevents HIF degradation and increases transcriptional activity. Therefore, the concentration of HIF-1 alpha increases in the cell. In contrast, HIF-1 beta remains stable under either condition. HIF-1 beta is a series of aryl hydrocarbon receptor nuclear translocator (ARNT) gene products. Diseases associated with HIF-1 beta dysfunction include hypoxia and renal cell carcinoma.
仅用于科研。不用于诊断过程。未经明确授权不得转售。
篇参考文献 (0)
生物信息学
蛋白别名: ARNT protein; Aryl hydrocarbon receptor nuclear translocator; bHLHe2; Class E basic helix-loop-helix protein 2; Dioxin receptor, nuclear translocator; hif 1; HIF-1-beta; HIF1 beta; hypoxia-inducible factor 1, beta subunit; Hypoxia-inducible factor 1-beta
基因别名: ARNT; BHLHE2; HIF-1-beta; HIF-1beta; HIF1-beta; HIF1B; HIF1BETA; TANGO
UniProt ID: (Human) Q5QP39
Entrez Gene ID: (Human) 405